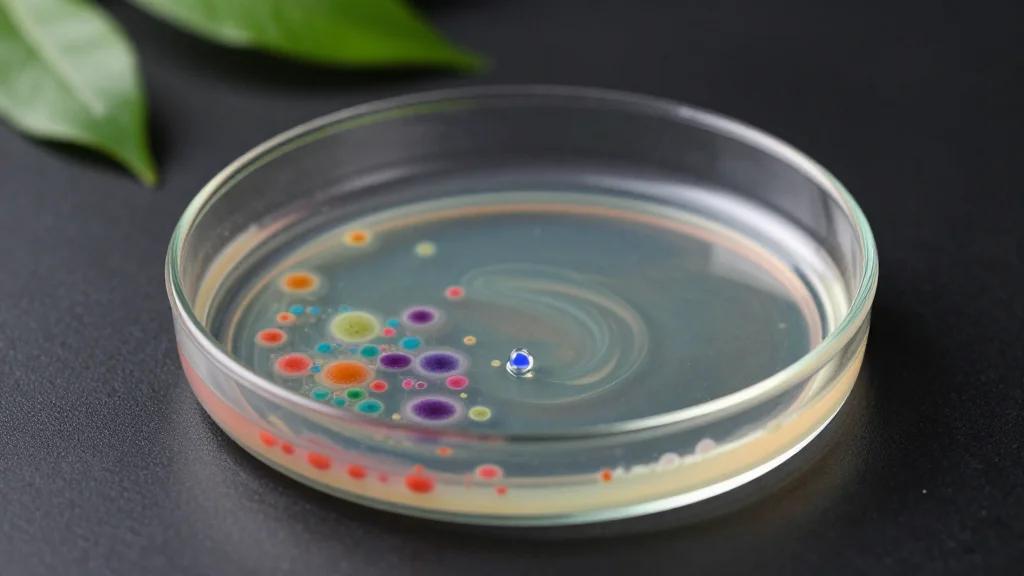
German Researchers Engineer Bacterial Consortium that Degrades Phthalate Plastics in 24 Hours

India Targets 2030 Drone Hub as Defence Minister Calls for Full Self‑Reliance
Defence Minister Rajnath Singh launched the National Defence Industrial Conclave in New Delhi, demanding a completely indigenous drone ecosystem by 2030. He warned that reliance on foreign components, especially from China, jeopardises strategic autonomy and highlighted the need for MSMEs to scale up.

China to Set National Post‑Quantum Crypto Standards Within Three Years, Expert Says
China is poised to issue national post‑quantum cryptography (PQC) standards by 2027, according to Tsinghua professor Wang Xiaoyun. The move follows a new five‑year plan that earmarks quantum tech as a strategic industry and signals a rapid shift in global...

Spinal Elements' 3D Printed Ventana A ALIF Devices Receives FDA 510(k) Clearance
Spinal Elements has received FDA 510(k) clearance for its 3D printed Ventana A anterior lumbar interbody fusion (ALIF) system, a device engineered with a hinged architecture to maximize bone graft volume and containment. The system employs a specialized additive‑manufacturing process...

KYND Partners Converge to Scale Cyber Underwriting Platform
KYND, a cyber risk analytics firm, has been selected by Converge, a US‑based cyber insurance MGA, to power its digital underwriting platform. The deal equips Converge with KYND’s real‑time vulnerability intelligence, Signals reports and rapid scanning tools to handle high...
German Researchers Engineer Bacterial Consortium that Degrades Phthalate Plastics in 24 Hours
Scientists at Germany's Helmholtz Centre for Environmental Research have assembled a three‑species bacterial consortium that can completely degrade diethyl phthalate at concentrations up to 888 mg/L within 24 hours at 30 °C. The discovery, published in Frontiers in Microbiology, demonstrates cross‑feeding synergy and...

Digital ID Wallets: How Banks Are Leading the Next Frontier in Secure, AI-Driven Financial Services
Banks are positioning themselves at the forefront of digital identity wallets, integrating AI-driven biometric verification to combat fraud. Industry analysts, like Lorena Roman of Raiffeisen Bank International, stress that collaboration among banks, regulators, and tech firms is essential for scaling...

Ex-Klarna Executive Joins Tide’s C-Suite
Bernie Miles, a former Klarna executive and ex‑CTO of PPRO, has been appointed chief data and technology officer at fintech platform Tide. In his new role, Miles will steer Tide’s transition to an AI‑first business‑management platform that bundles credit, accounting,...

Solarium Green Energy Shares Surge 8% After Launching 1 GW Solar Module Plant
Solarium Green Energy Limited saw its BSE‑listed shares climb nearly 8% after announcing the commissioning of a 1 GW solar module manufacturing facility in Ahmedabad. The plant, built at an estimated ₹900 million capex, is projected to generate more than ₹1,000 crore in...

XBOW Secures $120 Million Series C, Hits Unicorn Valuation as Autonomous Hacker Platform Scales
XBOW announced a $120 million Series C round led by DFJ Growth and Northzone, pushing its valuation past $1 billion. The funding will accelerate the rollout of its AI‑powered autonomous offensive security platform to Fortune‑500 enterprises worldwide. Investors cite the company’s proof that...

A Liquid Biopsy Blood Test May Improve Children's Survival of Cancer in Africa
Researchers from Oxford and Tanzania have validated a liquid‑biopsy blood test that identifies EBV‑positive Burkitt lymphoma with 98% accuracy. The assay cut the diagnostic timeline by an average of 40 days, allowing most patients to start therapy within a week of...

Why I Switched From ChatGPT to Claude (And What Finally Pushed Me Over)
Attorney Ernie Svenson explains why he abandoned ChatGPT for Anthropic's Claude, citing the CoWork feature that lets the AI interact directly with local files. He leveraged Claude’s Projects to build legal training courses in under three hours, generating quizzes automatically....

Molecule in Python Blood Could Pave Way for New Obesity Drugs, Scientists Say
Scientists have isolated a gut‑bacterial metabolite, pTOS, that spikes in Burmese python blood after feeding and dramatically reduces appetite in obese mice. When administered to mice, pTOS caused a 9% body‑weight loss over 28 days without affecting energy expenditure. The...

RCTs for Human-AI Evaluation
RAND’s new working paper investigates the use of randomized controlled trials—referred to as human uplift studies—to evaluate artificial‑intelligence systems. Drawing on interviews with 16 AI practitioners, the authors map methodological hurdles that arise throughout the trial lifecycle, from task definition...

Rep. Eric Swalwell's Private AI Company Raises Money, Questions
Rep. Eric Swalwell co‑founded Findraiser, an AI‑driven platform that scans campaign fundraising data. Dozens of Democratic campaigns, including Swalwell’s own congressional and gubernatorial bids, have paid the firm for its services. The company is close to profitability, valued between $100,001...

Online Grocery Shoppers Prioritize Health Over Taste
A Purdue University study of 1,200 U.S. consumers finds that health and nutrition now eclipse taste as the primary driver for online grocery shoppers, with only 37% ranking taste first. Nutritional targets and health goals were cited by 59% and...

Using ChatGPT and AI in Physical Therapy
In episode 383 of #AskMikeReinold, physical therapists discuss how AI—especially ChatGPT, Google Gemini, and niche tools like OpenEvidence—is being woven into daily practice. They highlight OpenEvidence’s ability to surface PubMed‑linked research with minimal hallucinations, while ChatGPT and Gemini assist with treatment...

The PC Era Is Dying. Welcome to the Collective Computer Era
The personal computer, once a garage‑born symbol of individual empowerment, is losing its central role as cloud and AI services consolidate processing power. Rising demand for AI‑optimized hardware is inflating component costs, pushing PCs toward a premium, niche market. Meanwhile,...

China Sits at the Top of America’s Cyber Threat List
The U.S. Intelligence Community’s 2026 Annual Threat Assessment places China at the top of the nation‑state cyber threat list, describing it as the most active and patient actor with persistent footholds inside American networks. Beijing’s strategy focuses on pre‑positioning access...

Funds Are Watching Prediction Markets But Not Using Them Yet, Report Finds
Institutional investors are increasingly monitoring prediction markets as a source of alternative data, but adoption remains limited. Hedge funds and macro investors show clear interest, yet few have integrated these signals into regular investment workflows. Polymarket and Kalshi dominate the...

Zalando Is Scaling up Its Use of AI-Powered Warehouse Robots
Zalando is rolling out AI‑powered warehouse robots to multiple European distribution centers. After a pilot where ten robots processed roughly 100,000 picks per day, the company plans up to fifty installations, starting in Germany and Italy and expanding to the...

Hacking a Robot Vacuum
A recent hack of a robot vacuum highlighted the pervasive insecurity of connected consumer devices. Manufacturers often ship IoT products with weak authentication, unencrypted communications, and no reliable patching process. The incident underscores a broader industry trend that prioritizes rapid...

The Uberization of UPL? How AI Is Outpacing the Unauthorized Practice of Law (Ken Crutchfield, Bill Henderson, Jim Doppke)
In this episode of Technically Legal, host Chad Main and guests Ken Crutchfield, Bill Henderson, and Jim Docky explore how large language models are challenging long‑standing unauthorized practice of law (UPL) rules. They discuss real‑world examples, such as a ChatGPT‑generated...

Kim Launches Enterprise AI Execution Layer
Kim, founded by legal‑tech pioneer Karl Chapman, has launched an execution layer that converts AI‑generated requests into deterministic, governed workflows for enterprises. The platform offers a no‑code configuration tool that integrates across existing systems, ensuring reliable outcomes without locking customers...

AI Scans 600k Posts, Powers NVIDIA Investor Prep
The Investor Report for NVIDIA. (I'm meeting in the morning with their venture arm, Inception). My AI reads 600,000 posts in minutes (it is a new kind of AI from Levangie Labs). And analyzes them. And tells me what's important so...

Logistics Provider Orders 75 eActros 600: High Fuel Prices Drive Transformation – Mercedes-Benz Receives Major Electric Truck Order From the...
Simon Loos, a Dutch logistics provider, ordered 75 additional Mercedes‑Benz eActros 600 trucks, raising its electric fleet to 210 units – the largest in the Netherlands and among Europe’s pioneers. The decision is driven by sustained high diesel prices and the...

Intuitive Surgical Recalls Stapler Reloads over Issue Linked to Patient Death
Intuitive Surgical announced a voluntary recall of its 8 mm SureForm gray stapler reload cartridges after four serious injuries and one patient death were linked to incomplete staple lines. The FDA issued an early‑alert notice, prompting the company to ask customers...

Promise of AI-Driven Efficiencies Draws Investors to Hotels, C&W Reports
European hotel investors remain bullish for 2026, driven by AI‑enabled cost efficiencies, according to Cushman & Wakefield. 58% plan to allocate more capital than in 2025, and 54% intend to be net buyers, while only 7% expect to sell. AI is...

A Third of Employees and Employers Agree There's No Time for AI Upskilling
Indeed’s UK Smarter Hiring report shows half of employers view AI and automation as the chief catalyst for skill changes over the next three to five years, yet one‑third of jobseekers and 40% of employers say they lack time for...

OnePlus Nord Buds 4 Pro with 55dB ANC, up to 54-Hour Battery Launched in India at ₹3,999
OnePlus has introduced the Nord Buds 4 Pro in India, priced at ₹3,999 (₹3,799 launch offer). The true‑wireless earbuds feature 12 mm dynamic drivers, Bluetooth 6.0, and active noise cancellation that can suppress up to 55 dB of sound across four ANC modes....

Terna Approves 3 GWh Storage Project: Italy Is Building Ever Larger Energy Storage Systems - Green Light for Airengy Mega-Project
Israeli developer Airengy Ltd. secured Terna’s approval to connect a 3 GWh lithium‑ion battery facility in Brindisi, Italy. The plant will deliver over 500 MW of power, supporting grid stability and renewable integration. The €230 million project, built in partnership with the Yehuda‑Levi...

How to Use TikTok's Verified Business Account Features and Local Feed
In this episode, Michael Stelzner, Jerry Young, and TikTok expert Kenya Kelly break down TikTok’s new Verified Business Account and the upcoming Local Feed. They explain how the free verification ties a profile to a real business, unlocking features like...

2C2P, M-Pay Partner for Sun PhuQuoc Airways' Payment Experience Across Asia
2C2P and M‑Pay have teamed up to launch the Payment Air Controller (PACO), a payment‑orchestration platform for Sun PhuQuoc Airways (SPA). The solution aggregates cards, digital wallets, QR codes and direct‑debit options through a single API, enabling smart‑retry routing across multiple...

Interview with AAAI Fellow Yan Liu: Machine Learning for Time Series
Yan Liu, elected AAAI Fellow for her work on machine learning for time‑series and spatiotemporal data, outlines the field’s evolution from statistical models to deep neural networks and now to general‑purpose foundation models. She highlights recent breakthroughs in zero‑shot and...

Accedo One and Magine Pro’s Leyra Delivers Unified OTT SaaS Platform
Accedo One and Magine Pro have launched Leyra, a joint‑venture SaaS platform that unifies their respective OTT technologies. The new offering blends Magine Pro’s subscriber‑lifecycle management with Accedo One’s streaming stack and Marketplace, delivering a single end‑to‑end solution. Leyra promises...

JFrog Agent Skills Registry Released
JFrog unveiled its Agent Skills Registry, a secure catalog that governs AI agent skills, models, and software packages. The registry is validated through early integration with NVIDIA, supporting the NVIDIA OpenShell runtime and AI‑Q Blueprint. It leverages Artifactory to scan,...

Day 150: Multi-Cloud Deployment Templates - Making Your Log System Cloud-Native
On day 150 the author shifts focus from building a high‑throughput log processing system to shipping it via multi‑cloud Infrastructure as Code templates. The IaC blueprints enable a single‑command deployment to AWS, Azure, or Google Cloud, turning containers, databases, caches,...

Buying Traffic: Does It Work?
Affiliates are increasingly turning to paid traffic as organic search becomes volatile, but success hinges on a simple margin test: earnings per click must exceed cost per click. High‑ticket SaaS, finance, and insurance offers provide enough commission to absorb higher...

Chainguard Introduces the Guardener
Chainguard unveiled the Guardener, an AI‑driven agent that automatically converts bloated, legacy Dockerfiles into minimal, zero‑CVE Chainguard container images. The tool rebuilds Dockerfiles layer by layer, validates functional equivalence, and delivers migration reports, cutting conversion time from weeks to under...

Traditional Channels Beat Digital as ‘Super Touchpoints’
A new DMA and Jicmail report finds traditional media outperform digital in trust, creativity, targeting, and measurement. Channels like TV, radio, out‑of‑home and direct mail—dubbed “Super Touchpoints”—deliver 25% higher effectiveness but are used in only 55% of campaigns. Effectiveness rises...

Probable and Possible: Why the Era of Probabilistic Computing Requires Real World Learning with an Entrepreneurial Mindset
The article argues that we are moving from deterministic to probabilistic computing, where AI models generate distributions of likely outcomes rather than single answers. This shift fuels agentic systems that can execute tasks faster and cheaper than human experts, expanding...

Small Cells Offer New Visibility Into City Flows
Bath has launched a city‑wide small‑cell rollout, partnering with Virgin Media O2, Ontix and the local council to bolster 5G capacity on busy shopping streets and tourist hotspots. The cells, mounted on existing lampposts, aim to alleviate network strain during...

Getting to the How and Why: AI Shows Its Work
AI explainability, once a barrier for insurance underwriting, is fading as next‑generation models deliver transparent insights. Modern AI now consistently outperforms traditional actuarial and rule‑based approaches across multiple underwriting tasks. By ingesting broader data sets and learning from outcomes, these...

Digest: Publicis Advises Clients to Avoid The Trade Desk; Meta Misses Illegal Financial Ads; Alibaba Forms New AI Business Group
Publicis Groupe told select clients to pause work with The Trade Desk after an independent audit flagged questionable fee applications and opaque cost reporting. The Trade Desk rejected the allegations, citing confidentiality constraints on the auditor’s data requests. Meanwhile, Meta...

The Genealogy of AI Slop: Generative AI Didn’t Invent It – It Learned It
The piece argues that generative AI did not create the phenomenon of “AI slop” but learned it from the abundance of vague, authority‑laden human content such as consulting frameworks, certification manuals, and best‑practice decks. By reproducing these patterns at machine...

From Spectator to Builder: Shape the AI Future
The first time I watched Steve Jobs’ 1983 Aspen keynote, it really struck me. Not because of the technology predictions. But because of the mindset behind them. Jobs said computers would become extensions of human creativity and potential. In 1983, that sounded bold. Today, with...

Full‑stack Ownership, Not Model Size, Builds AI Moats
Evaluating AI companies on model strength? Wrong lens. The ones pulling ahead own the whole stack. Nvidia: GPU + CPU + inference + agents + robotics + space. Anthropic: open-sourced the framework. OpenAI/Google adopted it. That's ecosystem lock-in. That's a moat. https://t.co/peRssqeTQf

Renewables and Heat Pumps Could Slash UK Gas Costs
😬UK gas prices just hit highest level since 2022😬 At current prices… * New wind & solar from latest "AR7" auction would cut the bill for UK gas imports by £5.5bn/y * A single (1) home heat pump would cut bill for gas...

AI Lily Pond: Which Day Are We Really On?
The AI Lily Pond: Are We on Day 29 or Day 30? by @Timothy_Hughes https://t.co/UeYxopffc9 @DLAIgnite #SocialSelling #DigitalSelling #Sales #SalesTips #SalesLeader #Salesforce #Marketing #Leadership #ArtificialIntelligence #Innovation #Technology #Tech #TechNews https://t.co/vons4157DG

Regional Nuclear Transparency Could Spark Diplomatic Dialogue
The case for diplomacy, with an interesting suggestion of regional nuclear transparency / power cooperation as a prize potentially large enough to motivate dialogue.

Design, Test, and Align Humans Before Scaling AI
Don't scale AI workflows before they're designed, tested, and understood. Clearly define roles, expectations, and how jobs will change. The human element is as crucial as the AI tool itself for successful adoption. #AIImplementation #WorkflowDesign https://t.co/BRuwIeZhHP